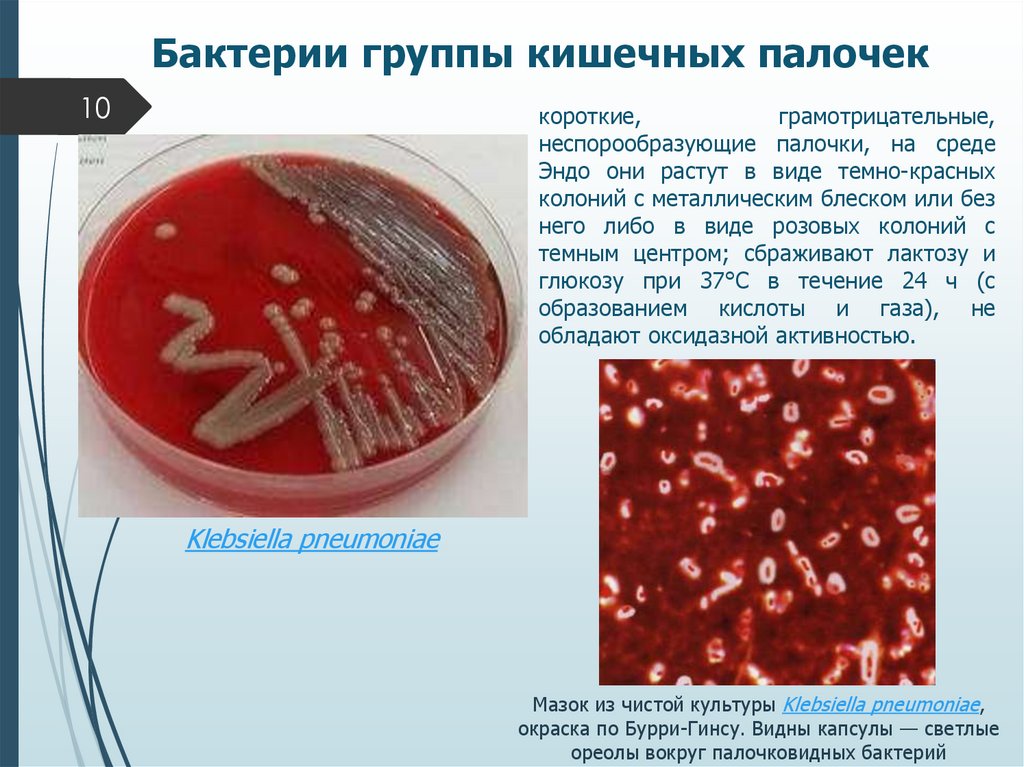
Бактерии группы кишечных палочек
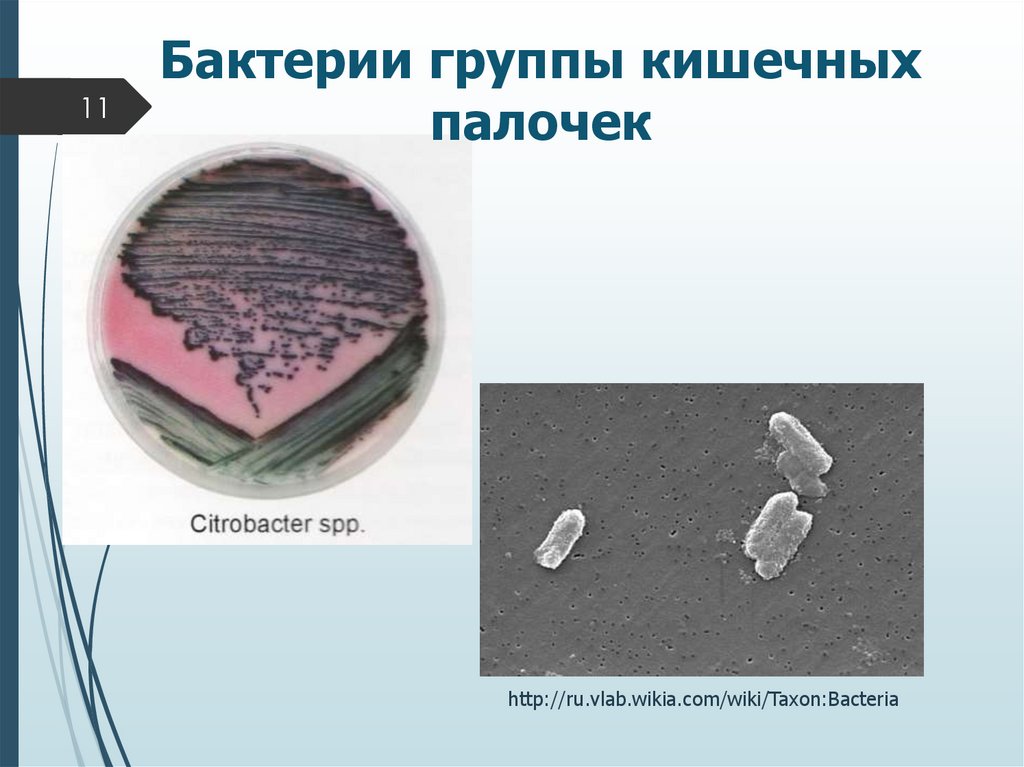
Бактерии группы кишечных палочек
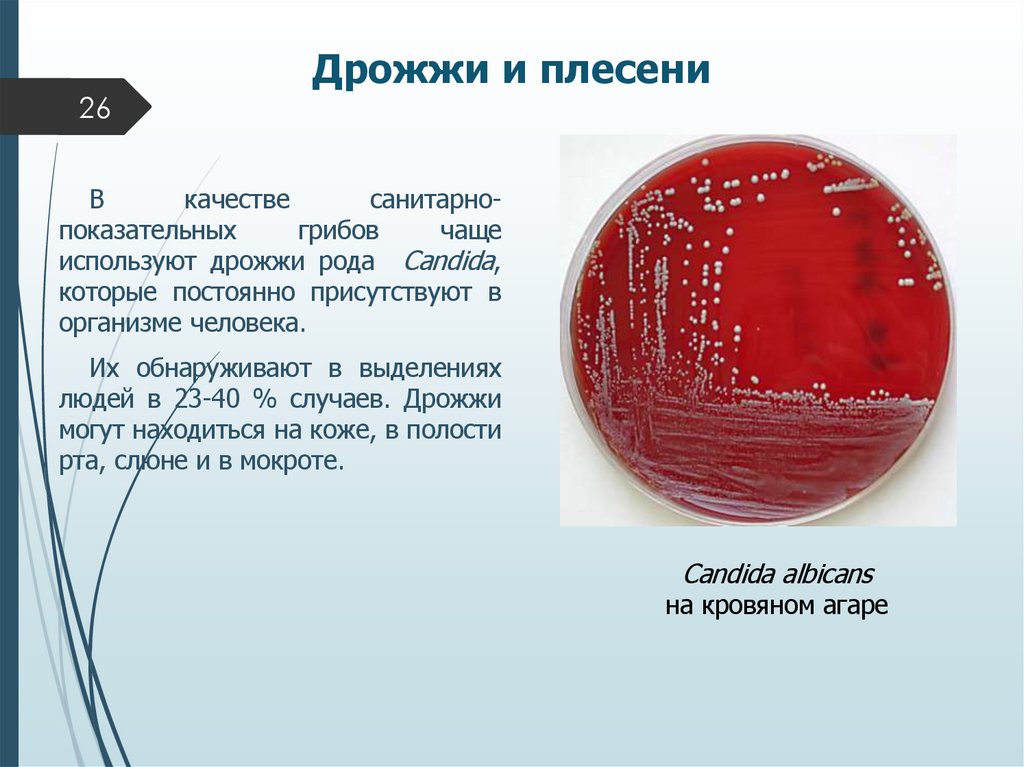
Дрожжи и плесени

Similar presentations:
Санитарная и пищевая микробиология. Общая бактериальная обсемененность
1.
Министерство науки и высшего образования Российской ФедерацииФЕДЕРАЛЬНОЕ ГОСУДАРСТВЕННОЕ БЮДЖЕТНОЕ
ОБРАЗОВАТЕЛЬНОЕ УЧРЕЖДЕНИЕ ВЫСШЕГО ОБРАЗОВАНИЯ
«ОРЕНБУРГСКИЙ ГОСУДАРСТВЕННЫЙ УНИВЕРСИТЕТ»
Химико-биологический факультет
Кафедра биохимии и микробиологии
Дисциплина:
Санитарная и пищевая микробиология
Тема: Санитарная микробиология.
Объекты изучения
Лекция для бакалавров
направления 06.03.01 –
«Биология» профиль
подготовки
«Микробиология»
Лектор: Дроздова Е.А.,
к.б.н., доцент
2. План:
1. История становления2. Санитарно-эпидемиологическая служба РФ
3. Принципы
исследований
санитарно-микробиологических
4. Понятие о санитарно-показательных микроорганизмах
5. Бактерии группы кишечных палочек
6. Энтерококки
7. Сульфитредуцирующие клостридии
8. Бактерии рода Proteus
9. Стафилококки
10. Дрожжи и бактериофаги
11. Общие требования в промышленности
3. Введение
3Санитарная микробиология – наука, изучающая микрофлору
окружающей среды и вызываемые ее жизнедеятельностью процессы,
которые
могут
непосредственно
или
косвенно
оказывать
неблагоприятное влияние на здоровье людей и окружающую среду.
Санитарная микробиология разрабатывает методы контроля за
санитарным состоянием воды, воздуха, почвы, пищевых продуктов и
предметов обихода.
Созданием
научно-обоснованных
нормативов
предельно
допустимых уровней воздействия различных факторов окружающей
среды на здоровье человека занимается Государственная
санитарно-эпидемиологическая
служба
Российской
Федерации. Это единая федеральная централизованная система
органов
и
учреждений,
осуществляющих
санитарноэпидемиологический надзор. В настоящее время имеется более 2000
гигиенических
нормативов,
в
которых
регламентируется
неблагоприятное воздействие на здоровье человека биологических, а
также химических и физических факторов.
4. История становления санитарной микробиологии как науки
4История становления санитарной
микробиологии как науки
Началом развития санитарной микробиологии можно
считать 1888 г., когда впервые французский врач Е. Массе
предложил считать кишечную палочку показателем фекального
загрязнения воды.
В 1963 году в нашей стране было утверждено «Положение о
государственном надзоре», в котором были указаны основные
задачи по организации работы санитарно-эпидемиологической
службы, подчеркнуты комплексность ее работы, определены
пути дальнейшего совершенствования санитарно-правового
законодательства, организация структуры его органов и
учреждений,
повышение
уровня
и
специализации
государственного санитарного надзора.
5. Государственная санитарно-эпидемиологическая служба РФ
5Государственная санитарноэпидемиологическая служба РФ
Государственная
санитарно-эпидемиологическая
служба
Российской Федерации – это единая федеральная централизованная
система органов и учреждений, осуществляющих государственный
санитарно-эпидемиологический надзор в Российской Федерации.
Организацию деятельности системы государственной санитарноэпидемиологической службы Российской Федерации осуществляет Главный
государственный санитарный врач Российской Федерации, он же
руководитель Федеральной службы по надзору в сфере защиты прав
потребителей и благополучия человека.
Структура государственной санитарно-эпидемиологической службы
Российской Федерации, ее задачи, функции, порядок осуществления ее
деятельности, порядок назначения руководителей органов и учреждений
указанной службы устанавливаются Положением о государственной
санитарно-эпидемиологической
службе
Российской
Федерации,
утвержденным Правительством Российской Федерации. Источник: Положение
о государственной санитарно-эпидемиологической службе РФ от 24 июля
2000 года № 554 // Собрание законодательства РФ. 2000. № 31 Cт. 3295.
6. Санитарно-микробиологическое исследование объектов
6Санитарно-микробиологическое
исследование объектов
Трудности обнаружения
возбудителей инфекционных
заболеваний
патогенные
микроорганизмы
находятся в
окружающей
среде постоянно
количество
патогенным
микроорганизмов
меньше
непатогенных
неравномерно
распространяются
в загрязненных
объектах
7. Санитарно-показательные микроорганизмы должны отвечать следующим основным требованиям:
7Санитарно-показательные
микроорганизмы должны отвечать
следующим основным требованиям:
должны обитать только в организме людей или животных и
постоянно обнаруживаться в их выделениях;
не должны размножаться или обитать в почве и воде;
сроки их выживания и устойчивость к различным факторам после
выделения из организма в окружающую среду должны быть равными или
превышать таковые у патогенных микробов;
их свойства должны быть типичными и легко выявляемыми для их
дифференциации;
методы их обнаружения и идентификации должны быть простыми,
методически и экономически доступными;
должны встречаться в окружающей среде в значительно
больших количествах, чем патогенные микроорганизмы;
в окружающей среде не должно быть близко сходных обитателей —
микроорганизмов.
8. Общая бактериальная обсемененность
8Общую бактериальную обсемененность продуктов
выражают показателем КОЕ, который характеризует
количество
колоний
мезофильных
аэробных
и
факультативно анаэробных м/о, выросших на плотной
питательной среде при посеве 1 г или 1 см3 субстрата и
культивировании посевов при 37 °С в течение 24-48
часов.
В ходе оценки состояния объекта определяют:
коли-индекс - количество СПМ в единице объема A
(литр, 1 г или 1 кубометр) материала или
коли-титр - наименьший объем (в мл), или весовое
количество (в г) материала, в котором еще
обнаруживаются санитарно- показательные микробы.
9. Бактерии группы кишечных палочек
9Под общим названием «Бактерии группы
кишечных
палочек»
(БГКП)
объединяются
бактерии
семейства
Enterobacteriaceae,
родов
Escherichia, Citrobacter, Enterobacter, Klebsiella.
По ГОСТ 2874-82 и ГОСТ 18963-73 – к БГКП
относятся грамотрицательные, не образующие спор
палочки, ферментирующие лактозу и глюкозу до
кислоты и газа при температуре 37 °С за 24 ч и не
обладающие оксидазной активностью.
БГКП выделяются в окружающую среду только из
кишечника человека и теплокровных животных
10. Бактерии группы кишечных палочек
10короткие,
грамотрицательные,
неспорообразующие палочки, на среде
Эндо они растут в виде темно-красных
колоний с металлическим блеском или без
него либо в виде розовых колоний с
темным центром; сбраживают лактозу и
глюкозу при 37°С в течение 24 ч (с
образованием кислоты и газа), не
обладают оксидазной активностью.
Klebsiella pneumoniae
Мазок из чистой культуры Klebsiella pneumoniae,
окраска по Бурри-Гинсу. Видны капсулы — светлые
ореолы вокруг палочковидных бактерий
11. Бактерии группы кишечных палочек
11Бактерии группы кишечных
палочек
http://ru.vlab.wikia.com/wiki/Taxon:Bacteria
12. Бактерии группы кишечных палочек
12Бактерии группы кишечных
палочек
E. coli
Enterobacter cloacae
13. Энтерококки
13Энтерококки
Энтерококки являются представителями нормальной
микрофлоры кишечника человека и животных и
выделяются в окружающую среду в довольно
значительных количествах (в 1 г фекалий до 108-109
жизнеспособных особей), но примерно в 10 раз меньше,
чем БГКП.
В настоящее время энтерококки считаются вторым
после БГКП санитарно-показательным микроорганизмом
при исследовании воды водоемов, особенно в местах
рекреации плавательных бассейнов, сточных вод,
почвы, предметов обихода.
14. Энтерококки
14Энтерококки
К энтерококкам относят два вида стрептококков
семейства Streptococcaceae рода Streptococcus — S.
faecalis (биовар liquetaciens и zymogenes) и S. faecium
(биовар durans).
Enterococcus faecalis light microscopy
Энтерококки в легочной ткани
больного пневмонией
15. Энтерококки
15Энтерококки
Преимущества бактерий данного рода:
Более устойчивы к химическим и физическим
воздействиям
Наличие избирательных средств
Несложность
видов
дифференциации
от
сходных
Удобны для оценки микробной загрязненности
продуктов, длительно хранящихся при низкой
температуре.
16. Сульфатредуцирующие клостридии
16Сульфатредуцирующие
клостридии
Клостридии являются обитателями кишечника
человека и некоторых теплокровных животных и
выделяются в окружающую среду с фекалиями в
сравнительно небольшом количестве - 106 в 1 г.
К
имеющим
санитарно-показательноезначение
относятся главным образом С. perfringens и С.
sporogenes, способные редуцировать сульфит в
сульфитных средах при 45 °С в течение 12-24 ч.
При
определении
санитарно-показательных
клостридии высчитывают количество их в 1 л воды или
в 1 г почвы (индекс клостридии).
Как правило, в не загрязненных фекалиями
образцах почвы клостридии не обнаруживаются.
17. Сульфатредуцирующие клостридии
17С. perfringens
С. sporogenes
Большим преимуществом С. perfringens перед кишечными палочками как
санитарно-показательными микроорганизмами является быстрая и технически
несложная индикация их в окружающей среде, не требующая последующей
идентификации.
18. Сульфатредуцирующие клостридии
18Сульфатредуцирующие
клостридии используются в
качестве
санитарнопоказательных
м/о
при
исследовании
пищевых
казеинатов,
колбасных
изделий, икры, специй,
пряностей и т.д.
В
1
г
казеината
допускается не более 200
клеток Cl. Perfiringens .
Clostridium perfringens,
окраска по методу Грама
19. Бактерии рода Proteus
19Бактерии рода Proteus
Бактерии группы протея широко распространены в
природе, участвуют в процессах аэробного гниения и
служат показателем присутствия органических веществ
животного происхождения в воде водоемов.
Протеи обнаруживаются в испражнениях только у 5-10
% здоровых людей, причем значительно чаще в летнее
время.
Их нередко обнаруживают в различных пищевых
продуктах, что в лучшем случае свидетельствует о
гнилостном распаде и порче их.
При массовом обсеменении употребленного в пищу
продукта
протеи
могут
вызвать
пищевую
токсикоинфекцию.
20. Бактерии рода Proteus
20Бактерии рода Proteus
Протеи
используют
при
санитарной
оценке
таких
продуктов как запеканка и пудинг
из творога. Они не должны
выявляться в 0,1 г продукта.
Бактерии
рода
Рroteus
являются
санитарнопоказательными
также
при
исследовании яичного порошка,
рыбы, икры.
Кроме того для оценки почвы
и воды открытых водоемов.
Proteus spp
http://cow-leech.ru/docs/index-9336.html
21. Стафилококки
21Стафилококки
Стафилококки
являются
представителями
нормальной
микрофлоры.
Основным
местом
локализации их служат слизистые
оболочки
верхних
дыхательных
путей
человека
и
некоторых
теплокровных животных, а также
кожные покровы.
Присутствуют стафилококки и в
кишечнике здоровых людей. В
окружающую среду — в воздух, на
предметы обихода — стафилококки
попадают со слюной и мокротой при
разговоре, кашле, чихании, пении, а
также с кожи, из мест воспалений и
раневых поверхностей.
http://uuncle.ucoz.ru/news/vidy_stafilokokkov_i_svjazannye_s_n
imi_zabolevanija/2012-11-19-49
22. Золотистый стафилококк
22http://skachatkartinki.ru/tags.php?text=%F1%F2%E0
%F4%E8%EB%EE%EA%EE%EA%EA
основной
человеческий
патоген,
носителями которого
могут быть до 70 % здоровых
людей и который может привести
к таким тяжелым состояниям, как
инфекции
глубоких
тканей,
остеомиелит
и
хронические
легочные
инфекции,
которые
очень трудно поддаются лечению
антибиотиками.
Ключевой
характеристикой
этих инфекций является то, что
рецидивы
могут
происходить
спустя месяцы и даже годы после
кажущегося излечения.
23. Стафилококковые поражения кожи
23http://www.medkurs.ru/news/36965.html
Новое исследование, посвященное
золотистому
стафилококку
(Staphylococcus aureus), бактерии,
ответственной за развитие тяжелых
хронических инфекций, выяснило, как
бактериям удается прятаться внутри
клеток-хозяев, ускользая от внимания
иммунной системы и многих видов
антибактериального лечения.
Исследование, опубликованное в
издании Европейской организации
молекулярной биологии «Molecular
Medicine»,
доказало,
что
такая
особенность,
как
«переключение
фенотипа»,
дает
возможность
бактериям адаптироваться к условиям
окружающей среды, пребывать в
латентном состоянии внутри клетокхозяев и становиться источником
рецидивирующих инфекций.
24. Стафилококки
24Определенное
количество
исследуемого материала засевают
для накопления стафилококков в
солевой бульон, например: 1 мл (г) в
пробирку с 5 мл среды, инкубируют
при 37 °С в течение 24 ч.
При наличии роста (помутнении
среды) делают высевы на желточносолевой агар для
получения
изолированных колоний, которые
затем
идентифицируют
по
культуральным
свойствам,
морфологии (в мазке по Граму),
ферментации глюкозы и маннита,
наличию плазмокоагулазы.
S. aureus
25. Стафилококки в качестве санитарно-показательных микроорганизмов
25Стафилококки в качестве санитарнопоказательных микроорганизмов
Стафилококки
рекомендуются
в
качестве
санитарнопоказательных
микроорганизмов
для
воздуха
закрытых
помещений (особенно хирургических, детских стационаров, в
отделениях реанимации и интенсивной терапии и родильных
отделений).
Стафилококки обладают и большей устойчивостью к
различным химическим и физическим факторам воздействия.
Исходя
из
большей
резистентности
стафилококков
к
дезинфицирующим веществам (особенно препаратам хлора),
(Favero с соавторами) в 1964 г. предложено применять
стафилококки
в
качестве
санитарно-показательных
микроорганизмов загрязненности воды в зонах рекреации
водоемов, плавательных бассейнов и др.
26. Дрожжи и плесени
26Дрожжи и плесени
В
качестве
санитарнопоказательных
грибов
чаще
используют дрожжи рода Candida,
которые постоянно присутствуют в
организме человека.
Их обнаруживают в выделениях
людей в 23-40 % случаев. Дрожжи
могут находиться на коже, в полости
рта, слюне и в мокроте.
Candida albicans
на кровяном агаре
27. Бактериофаги в качестве санитарно-показательных микроорганизмов
27Бактериофаги в качестве санитарнопоказательных микроорганизмов
При исследовании питьевой
воды определяют наличие и
количество колифагов.
Колифаги – бактериальные
вирусы, способные лизировать
кишечные
палочки
рода
Escherichia,
они
являются
индикаторами очистки питьевой
воды
в
отношении
энтеровирусов.
28. Вода
28В
соответствии
с
действующими
нормативными
документами
контролю
подлежат:
• вода питьевая (центрального
и местного водоснабжения);
•вода плавательных бассейнов;
• вода открытых водоёмов;
• сточные воды;
вода
очищенная
для
приготовления лекарств;
• вода для приготовления
инъекционных
растворов
и
глазных капель
29. Почва
29Предупредительный надзор осуществляют:
а) при планировке, строительстве и реконструкции вновь
заселяемых участков и населенных мест;
б) при выборе участков для строительства
лечебно-профилактических и аптечных учреждений, санаториев,
детских
учреждений;
в) при решении вопросов водоснабжения и канализации
населенных территорий;
г) при санитарной оценке пляжей, мест коллективного
отдыха и т.д.
Текущий санитарный надзор осуществляют:
а) при оценке санитарного состояния почвы и ее способности
к самоочищению после загрязнений (например, почву детских
садов, больниц, зон отдыха исследуют 2 раза в год);
б) при контроле за почвенными и биотермическими методами
обезвреживания сточных вод и отбросов 1-4 раза в месяц);
30. Требования к микробиологической чистоте почв
30Требования к
микробиологической чистоте
почв
Категория
почвы
Чистая
Титр
БГКП*
Титр
нитрифицирующих
бактерий
Титр
клостридий
Индекс
термофиль-ных
микроорганизмов**
≥1,0
≥0,1
≥0,001
10² - 10³
Загрязненная
0,9 - 0,01
0,09 - 0,001
0,009 – 0,0001
10³ – 105
Сильно
загрязненная
≤0,0009
≤0,0009
≤0,00009
1 105 – 4 106
Примечание: * - наименьшее количество материала (г), в котором еще
обнаруживаются СПМО ; ** - количество особей СПМО в 1г исследуемой
почвы
31. Воздух
31Воздух
Показателями
биологического
загрязнения
воздуха
помещений являются стрептококки и стафилококки.
При санитарно-бактериологическом исследовании
воздуха проводят:
1) определение общей бактериальной обсемененности
воздуха (общее число бактерий в 1 м3);
2) выявление саyитарно-показательных микроорганизмов;
3) по эпидемическим показаниям выделение вирусов и
патогенных бактерий из воздуха закрытых помещений;
4)
при
исследовании
атмосферного
воздуха
дополнительное
определение
качественного
состава
микрофлоры с учетом наличия спорообразующих аэробов и
анаэробов, которые служат показателем загрязненности
воздуха микроорганизмами почвы.
32. Методы отбора проб воздуха для бактериологического исследования
32Методы отбора проб воздуха для
бактериологического исследования
1) аспирационные, основанные на активном
просасывании воздуха с помощью различных
приборов;
2)
седиментационные,
основанные
на
принципе механического оседания микробов.
Пробы воздуха берут на уровне сидящего или
стоящего человека, выделяя одну точку взятия проб
на каждые 20 м2 площади.
33. Пищевые продукты
33Пищевые продукты
Гигиенический контроль пищевых продуктов
предусматривает их оценку по следующим
показателям:
величине общей микробной обсемененности (ОМЧ);
наличию БГКП;
присутствию условно-патогенных бактерий (кишечной
палочки, золотистого стафилококка, антракоидной
палочки, протеев, клостридий);
наличию патогенных микроорганизмов (сальмонелл и
др.);
присутствию специфических возбудителей микробной
порчи продукта.
34. Требования к микробиологическим показателям некоторых пищевых продуктов
34Требования к микробиологическим
показателям некоторых пищевых продуктов
Микробиологические критерии доброкачественности
Вид продукта
Молоко сырое
(высший сорт)
ОМЧ
(КОЕ/г
(мл))
3 105
Количество продукта, в котором не допускается присутствие
бактерий
БГКП
S. aureus
Клостридий
Патогенных (в том
числе сальмонелл)
−
−
−
−
Молоко
пастеризованное
(А)
5 104
1 см3
1 см3
−
−
Кисломолочные
напитки
−
−
1 см3
−
−
00,01г
−
−
−
1г
1г
0,01г
25,0г
Мясо
замороженное
1 104
Колбасные
изделия вареные
1 10 3
35. Заключение
35Заключение
С
помощью
санитарно-микробиологических
исследований решают вопрос о наличии или степени
вероятности присутствия опасных для человека
микробов или их токсинов в объектах внешней среды
(воде,
воздухе,
почве,
пищевых
продуктах,
лекарствах, различных материалах, оборудовании и
др.).
Комплексное
санитарно-микробиологическое
исследование включает: определение косвенных
показателей неблагополучия — общей микробной
обсемененности (микробного числа), титра или
индекса санитарно-показательных микробов, степени
микробной порчи;
36.
Благодарюза
внимание!
36

medicine
medicine biology
biology








